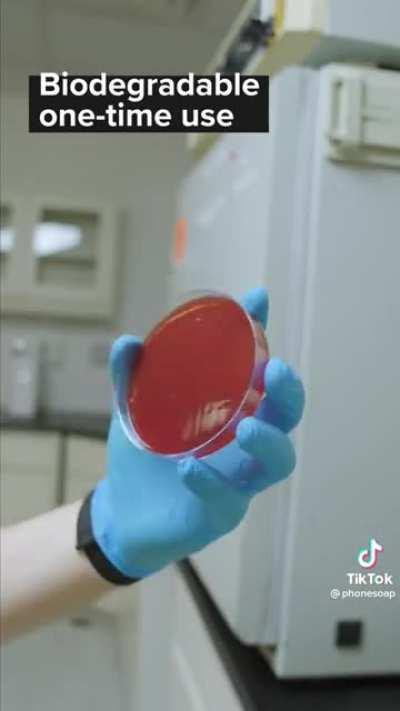

TikTokCurated
TikTokCurated
Browse Other Categories
- ArianaGrandeHands
- blackpanther
- BreckieHillM3GA
- Camfromtheking
- da_sports_lounge
- DogsWhoYell
- elizadenizfam
- infinityblade
- IShowSpeedd
- kratommemes
- Onepiecebikini
- productivity
- RandomRedditorWithNo
- shaniboni
- spidermanps5
- tallyhall
- theouterworlds
- toradora
- twopanelgarfield
- UkraineRussianWarNews
- u_anisyia
- u_Brunin17
- u_calimmgo
- Video_0
- VORONDesign